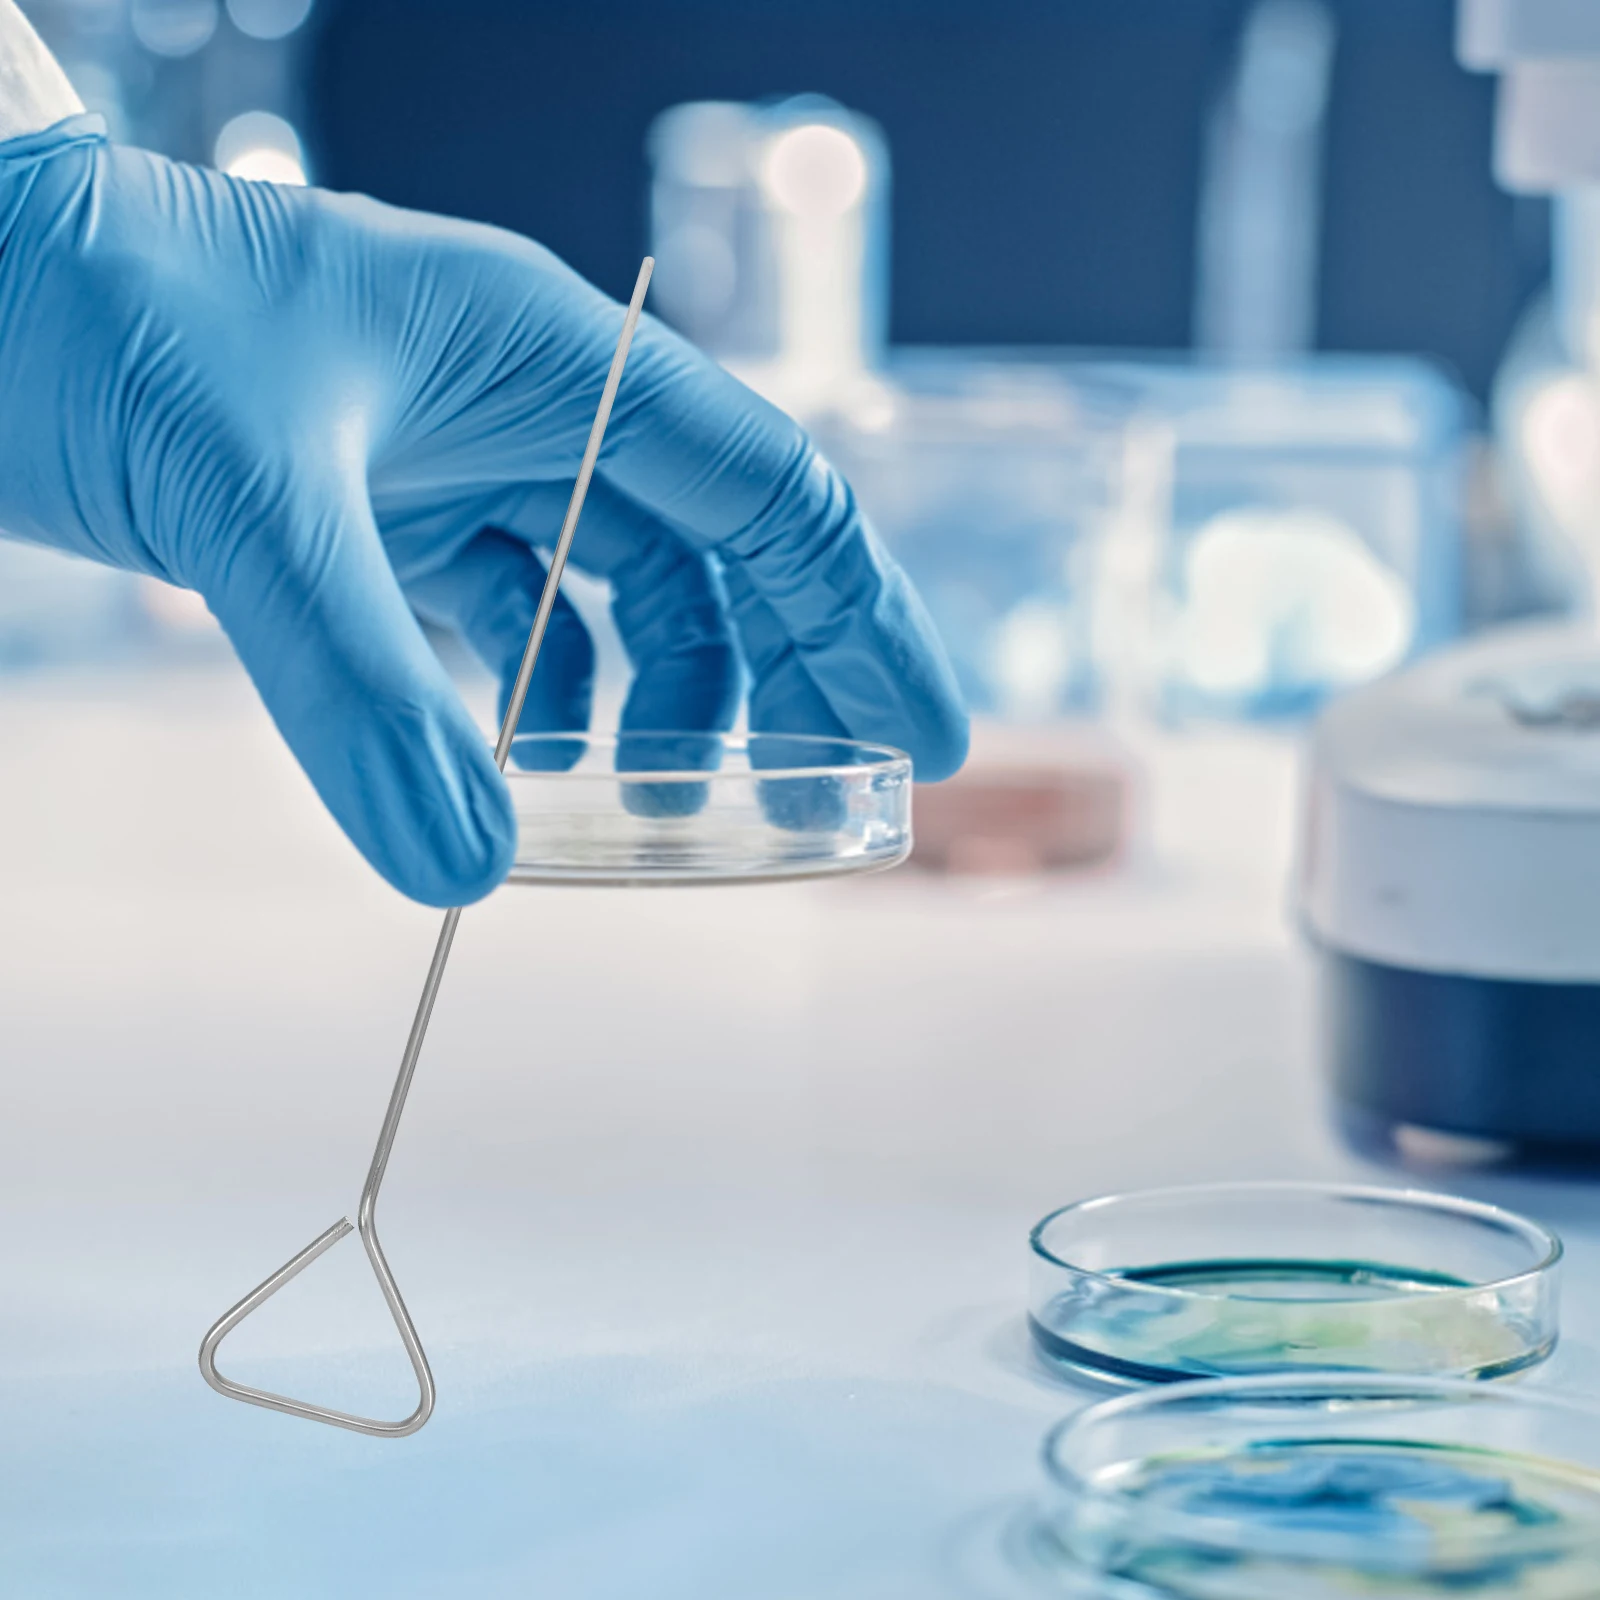
6pcs Stainless Steel Petri Dish Triangle Cell Spreader Lab Tools Coating Rod Science Lab Accessories Cell Spreading Sticks

Набор женских трусиков стринги Nicoletta 7 шт., Синий
Описание
Размеры трусиков неделек стринги Nicoletta
Размер Nicoletta
Размер Украина
Обхват бёдер
Высота
Наличие
M
42-44
82-87
17
ЕСТЬ
L
44-46
88-92
18
ЕСТЬ
XL
46-48
92-96
19
ЕСТЬ
Набор женских трусиков Женские трусики стринги фирмы Nicoletta изготовлены в Турции. Материал хлопок 95%, эластан 5%. В набор входят семь трусиков одного размера. Цвет синий, бежевый, белый.
Уважаемые клиенты - пожалуйста пишите нужный Вам размер трусиков в комментарии к заказу СОГЛАСНО ТАБЛИЦЕ РАЗМЕРОВ !
Вы можете купить трусики недельки в Киеве, а так же заказать набор женских трусиков неделек с доставкой по Украине !
Производитель Турция
Прямые поставки с фабрики
Товар в наличии / Свой склад
Реальные фото
Настоящие отзывы клиентов
Быстрое оформление
Отправка ежедневно до 17.00
Гарантия / Обмен
Способы оплаты:
Наложенный платёж / Перевод на карту Приват Банка
Как мы работаем
1. Вы оставляете заявку
2. Менеджер уточняет детали
3. Оформляем заказ и сообщает ТТН
4. Отправляем посылку Для оформления заказа необходимы:
Город доставки
Ф.И.О. получателя Номер мобильного телефона получателя
Номер отделения Новой почты или её адрес
Код товара / количество единиц товара
Способ оплаты
Смотрите весь асссортимент на нашем сайте:
www.trend-top.in.ua
Размер Nicoletta
Размер Украина
Обхват бёдер
Высота
Наличие
M
42-44
82-87
17
ЕСТЬ
L
44-46
88-92
18
ЕСТЬ
XL
46-48
92-96
19
ЕСТЬ
Набор женских трусиков Женские трусики стринги фирмы Nicoletta изготовлены в Турции. Материал хлопок 95%, эластан 5%. В набор входят семь трусиков одного размера. Цвет синий, бежевый, белый.
Уважаемые клиенты - пожалуйста пишите нужный Вам размер трусиков в комментарии к заказу СОГЛАСНО ТАБЛИЦЕ РАЗМЕРОВ !
Вы можете купить трусики недельки в Киеве, а так же заказать набор женских трусиков неделек с доставкой по Украине !
Производитель Турция
Прямые поставки с фабрики
Товар в наличии / Свой склад
Реальные фото
Настоящие отзывы клиентов
Быстрое оформление
Отправка ежедневно до 17.00
Гарантия / Обмен
Способы оплаты:
Наложенный платёж / Перевод на карту Приват Банка
Как мы работаем
1. Вы оставляете заявку
2. Менеджер уточняет детали
3. Оформляем заказ и сообщает ТТН
4. Отправляем посылку Для оформления заказа необходимы:
Город доставки
Ф.И.О. получателя Номер мобильного телефона получателя
Номер отделения Новой почты или её адрес
Код товара / количество единиц товара
Способ оплаты
Смотрите весь асссортимент на нашем сайте:
www.trend-top.in.ua
Характеристики
| Color: | Синий |
| Бесшовное: | Нет |
| Количество в упаковке: | 7 шт. |
| Международный размер: | L |
| Посадка: | Средняя посадка |
| Производитель: | Nicoletta |
| Состав: | Хлопок 95%, эластан 5% |
| Страна производитель: | Турция |
| Тип ткани: | Хлопок |
| Тип трусов: | Стринги |
| Узоры и принты: | Абстрактный принт |
График изменения цены & курс обмена валют
Пользователи также просматривали

652.74 грн.
200Pcs Christmas Cellophane Bags Clear Candy Treat Bags with 300Pcs Ties, 4 Styles Gift Wrapping Goodie Bags
aliexpress.ru
1,386.03 грн.
Черный корпус для мотоциклетного прибора, одометра, спидометра, корпус 2003 2004
aliexpress.ru
325.95 грн.
2/4/5PCS Polishing Blade Sharp Ultra-thin Glass Cutting Disc Brazing Grinding Polishing Cutting 100mm Cutting Blade
aliexpress.com
796.63 грн.
Motorcycle Kickstand Tip Fat Foot Side Stand Support Extension For Honda CRF250X CRF450X CRF450RX CRF150F CRF230F CRF 250L 250M
aliexpress.ru
193.81 грн.
Creative Frosted Clown Phone Case Cover for IPhone 14 Plus 11 12 13 14 Pro Max Shockproof Cases for IPhone 14 Case
aliexpress.ru
1,485.45 грн.
Природный Gebi Hetian кварцит нефритовый браслет ледяной прозрачный фиолетовый браслет женский Фиолетовый Гибискус кольцо ювелирные изделия
aliexpress.ru
704.34 грн.
Подлокотник для хранения Alfa Romeo Giulia 2017, черный поднос с нескользящим ковриком, коробка для перчаток и телефона
aliexpress.ru
453.90 грн.
Vintage Goth Multi Geometric Clavicle Necklaces For Women Girl Punk Collares Trend Stainless Steel Jewelry Valentine's Day Gifts
aliexpress.ru
3,741.10 грн.
Outdoor furniture chair foldable stool folding stool sillas camping foldable chair muebles Folding Camping Chair with Footrest
aliexpress.com
930.03 грн.
Cotton Bohemian Sunflower with Tassels Curtain Thick Blackout Curtains for Living Room American Vintage Drape Kitchen Valance
aliexpress.com
60.83 грн.
Korean Flower Stud Earrings For Women New Sweet Asymmetric Flowers Earring Acrylic Floral Elegant Earrings Girl Wedding Jewelry
aliexpress.com
490.82 грн.
Safty Pet Grooming Scissors Round Head Professional Stainless Steel Dog Hair Scissors Pets Shears Animal Cutting Portable Set
aliexpress.com
181.22 грн.
6pcs Silicone Cover Stretch Lids Reusable Airtight Food Wrap Covers Keeping Fresh Seal Bowl Stretchy Wrap Cover Kitchen Cookware
aliexpress.com
116.20 грн.
10pcs/pack Cartoon Black Briquettes Charms Dangle Big Eyes Golden Tone Metal Earring Pendants DIY Fashion Jewelry Accessory
aliexpress.com
1,547.96 грн.
Новая высококачественная кожаная мужская повседневная обувь, кроссовки на шнуровке, Мужские дышащие кроссовки, уличные кроссовки
aliexpress.ru
477.39 грн.
Женская куртка с длинным рукавом Осенний Блейзер приталенный Повседневный офисный женский двубортный Блейзер на пуговицах уличная одежда
aliexpress.com
7,251.06 грн.
Музыкальный инструмент Rosewood Erhu для начинающих, для взрослых и детей, универсальный Национальный музыкальный инструмент, лук Erhu из эбеновог...
aliexpress.com
833.13 грн.
Новая книга комиксы Рисунок мультфильм Q версия персонажи картина в стиле аниме техника учебник
aliexpress.ru
2,058.49 грн.
Designer Luxuyy Women Bag Oil Wax Cow Leather Shoulder Bag Diamond Lattice Crossbody Bag For Female
aliexpress.com
823.06 грн.
waterproof children School Bags boys large primary school Backpacks kids satchel Schoolbag Orthopedic Backpack mochila infantil
aliexpress.com
2,200.00 грн.
Смартфон Blackview A20 Gold экран 5,5" 4 ядра, 1/8GB батарея 3000mah- бюджетный безрамочный телефон, Black
prom.ua
7,650.65 грн.
Роллеты серия STANDART на окна и двери в профиле PD55 2500 х 2000, Пружинно-Инерционный Механизм, Самовывоз
prom.ua
480.00 грн.
Провода высоковольтные Renault Logan (Рено Логан) 1.4/1.6 Champion(Бельгия) 224404252R
prom.ua
59.15 грн.
Новинка весны и осени 2021, женские носки-трубочки, серия масляной живописи, индивидуальные красочные студенческие женские носки для скейтборда
aliexpress.ru
111.17 грн.
Breathable Overalls Stylish Puppy Costume Lightweight Pet Clothes Stripe Pattern Outdoor Party Daily Wear Small Dog Summer
aliexpress.ru
231.56 грн.
Funny Boil Crawfish T-Shirt, When Life Gives You Lemons Graphic Tee, Women's Men's Seafood Lover Top, Cute Foodie Pun Gift Shirt
aliexpress.ru